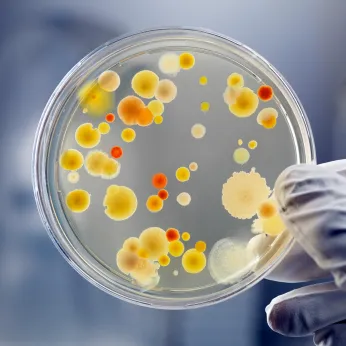

ARL Bio Pharma
Exhibitor
Information
ARL Bio Pharma is a contract testing laboratory that assists biotechnology and pharmaceutical innovators in developing safe and effective therapies. Our laboratory offers comprehensive analytical and microbiological testing to evaluate product safety, stability, and quality at every stage of drug development, from formulation to regulatory submission.
Leveraging comprehensive technologies such as high-resolution mass spectrometry, qPCR, and ELISA, we analyze the molecular structure, purity, and consistency of small molecules, monoclonal antibodies, peptides, and cell and gene therapies, empowering clients to make informed decisions and expedite their product’s time-to-market.
ARL Bio Pharma is FDA-registered, DEA-licensed for Schedules I through V, and ISO 17025:2017 accredited.